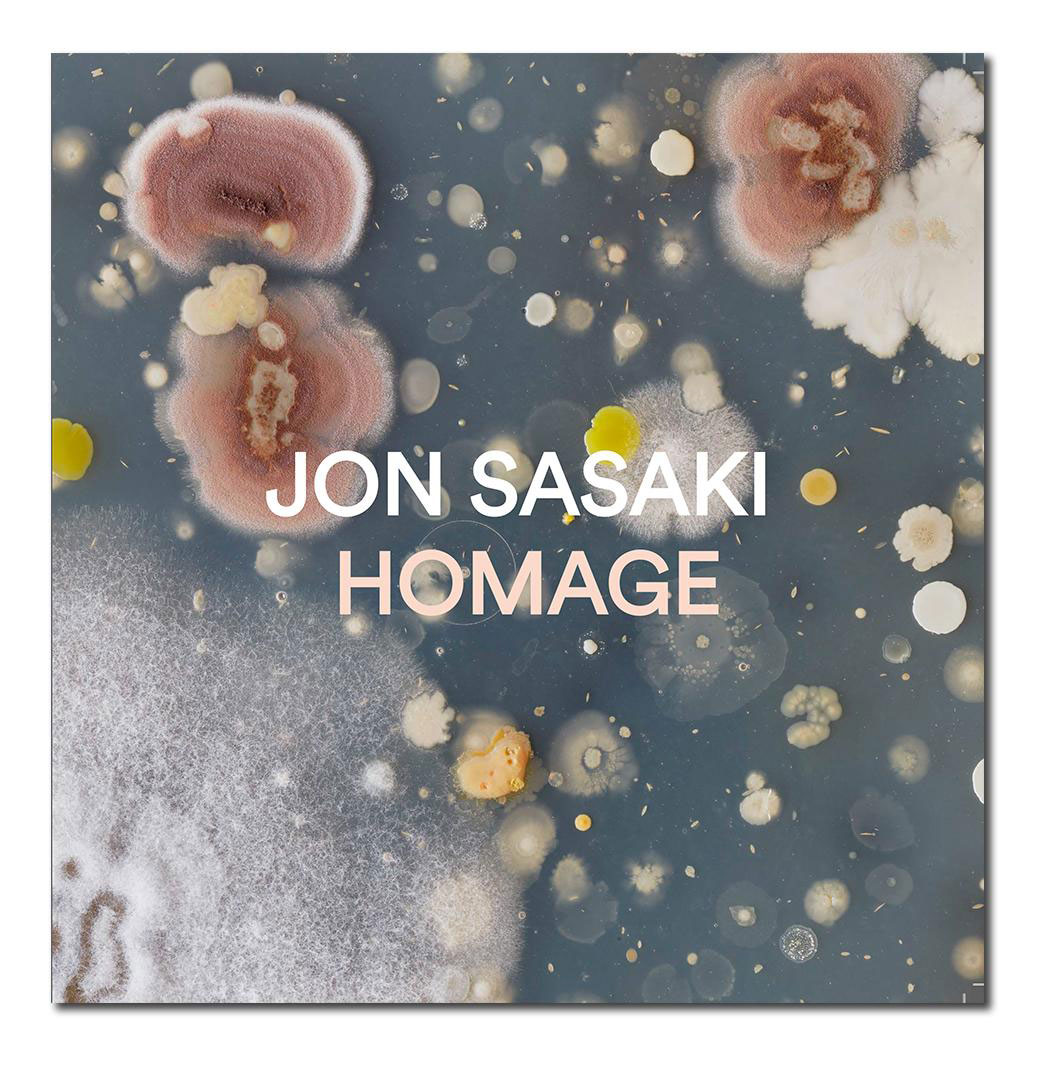
jonsasakihomagecover_v2
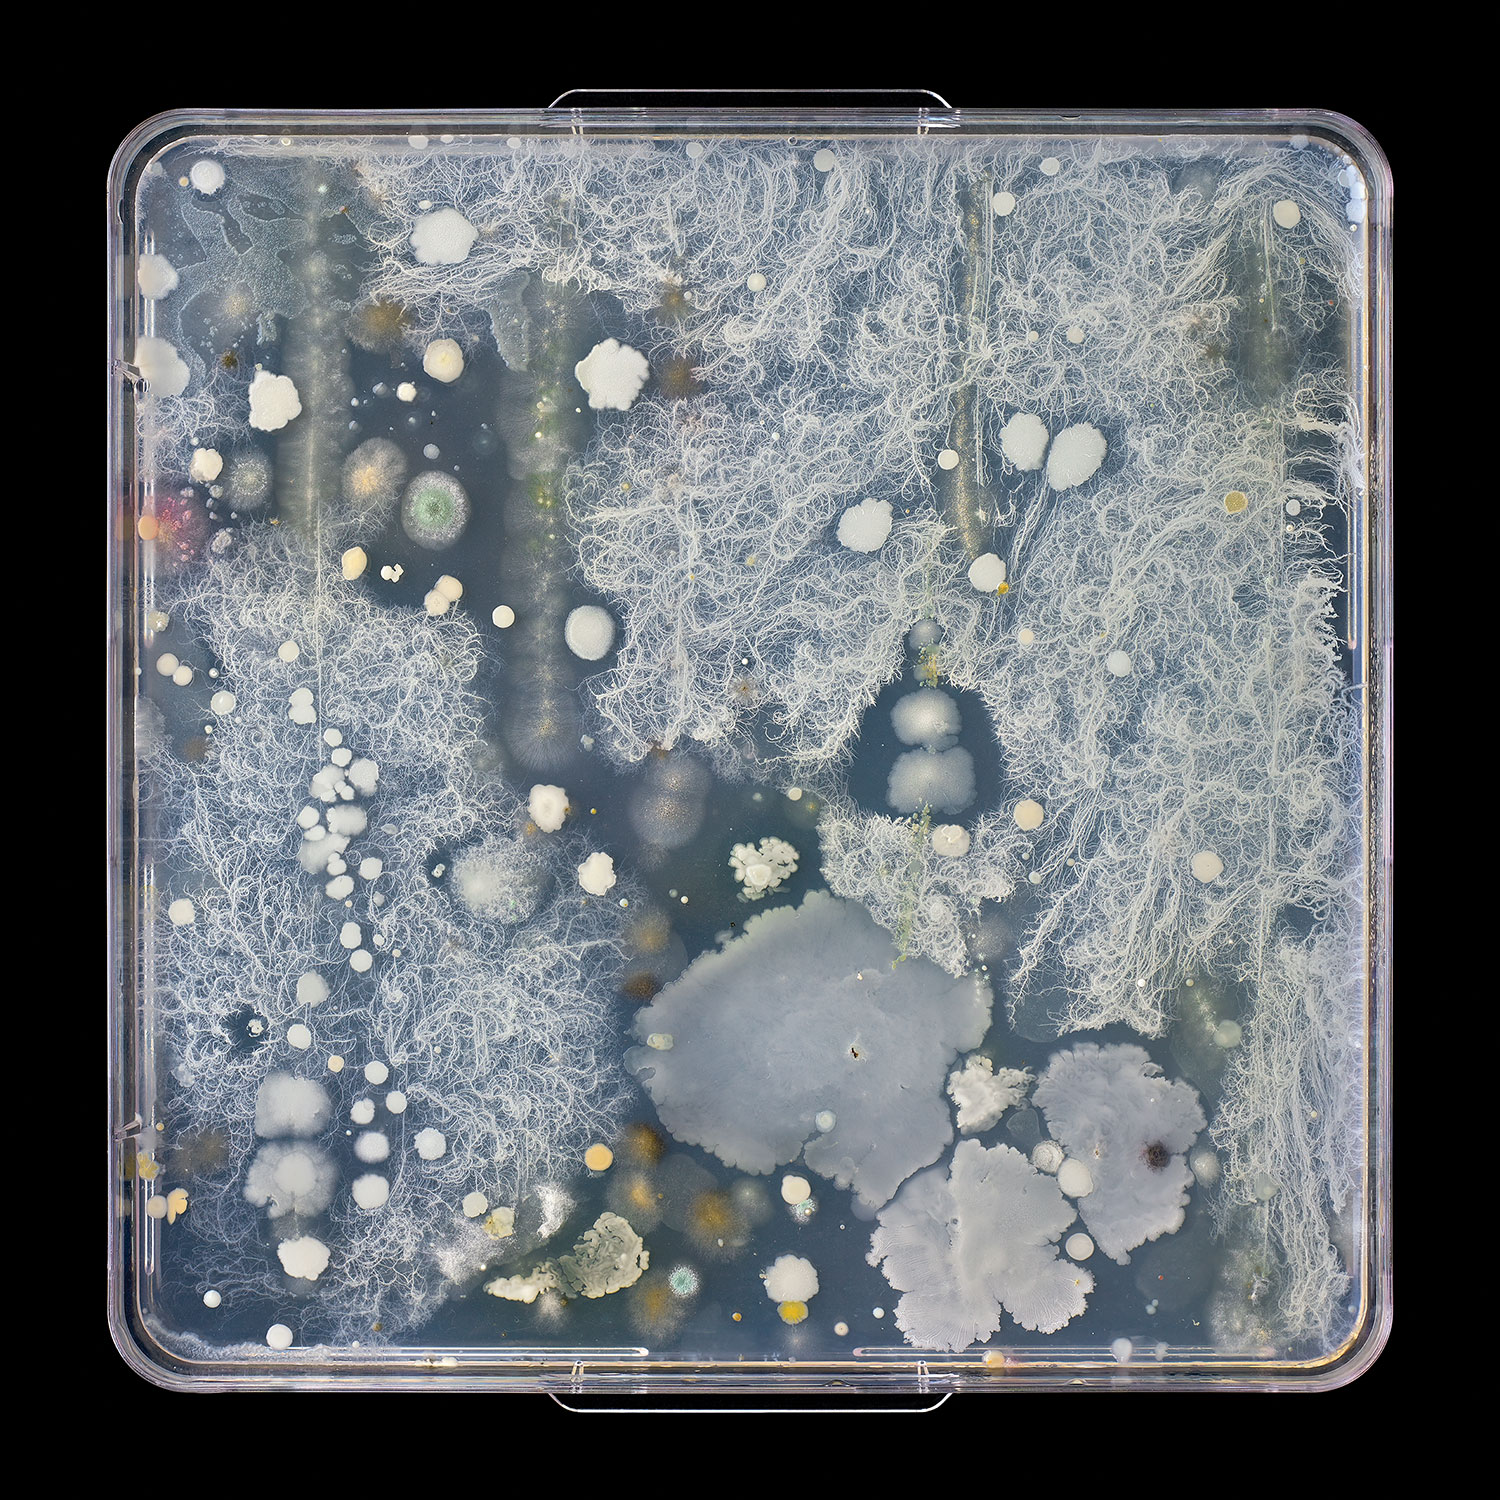

Celebrating the Group of Seven with Jon Sasaki
Celebrating the Group of Seven with Jon Sasaki
May 7, 2021
3 pm
About the talk
On the anniversary of the Group of Seven’s first exhibition, join McMichael Chief Curator Sarah Milroy in conversation with Jon Sasaki on the subject of reframing the landscape painting genre through the lens of photography.
About the exhibition
Jon Sasaki: Homage a suite of photographs depicting petri dishes with bloomed bacterial cultures derived from swabs of the palettes and easels used by members of the Group of Seven and Tom Thomson, objects held in the archives of the McMichael Canadian Art Collection. These large-scale works are monumental in scale, yet they reveal microscopic detail, affirming a playful reverence towards the Group’s legacy while reframing the genre of landscape painting through the lens of photography.
Art lovers can also purchase a copy of Jon Sasaki: Homage through the Gallery Shop. Your purchase directly sustains the Gallery and its mission. Order your copy today.
Consider a donation to help keep our programming free. We truly appreciate your generosity in support of the art of Canada.
Microbes Swabbed From an Easel
Thought to Have Been Used by Frank Johnston, 2020
archival print
91.44 x 91.44 cm
Image courtesy of the artist and Clint Roenisch Gallery
Watch the talk
